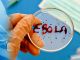
Эбола. Источник - http://www.khabar.kz/

Антон Семикин родился в 1983 году. Окончил Рязанский Государственный университет (РГПУ) по специальности журналистика. Работал сначала на ТВ, потом в печатной прессе, потом – в сетевых СМИ. В настоящий момент сотрудничает с ресурсами Каспаров.Ru (с 2007 года), "Особая буква" и "Русский журнал". Ведет блог ursooloff.livejournal.com/